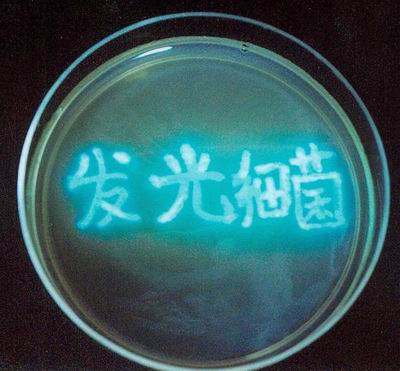

發(fā)光細(xì)菌方法簡介
近年來,水污染問題日益嚴(yán)重,與此同時(shí)也開發(fā)出許多靈敏、有效的環(huán)境監(jiān)測方法,這 些方法可以劃分為兩類:分析技術(shù)和生物監(jiān)測。其中分析技術(shù)常常用于廢水常規(guī)指標(biāo)的測試, 但不能反應(yīng)水質(zhì)綜合毒性的大小。傳統(tǒng)的生物監(jiān)測以水蚤、藻類或魚類為受試對象,雖然能 反映毒物對生物的直接影響,但是這些方法的最大缺點(diǎn)是實(shí)驗(yàn)周期長,實(shí)驗(yàn)過程比較繁瑣。 針對傳統(tǒng)生物毒性檢測方法的不足,研究和開發(fā)新型生物毒性監(jiān)測技術(shù)——發(fā)光細(xì)菌法。該 方法以簡便的操作方式、測量結(jié)果一目了然,受到了科研單位和企業(yè)的青睞。
自 1672 年 R.Boyle 觀察到發(fā)光的菌體所發(fā)出的光易被化學(xué)物質(zhì)抑制后,許多科學(xué)家 相繼對細(xì)菌的發(fā)光效應(yīng)進(jìn)行了大量的研究。本世紀(jì) 70 年代至80 年代初,國外科學(xué)家首次從 海魚體表分離和篩選出對人體無害,對環(huán)境敏感的發(fā)光細(xì)菌,用于檢測水體生物毒性,現(xiàn)已 成為一種簡單、快速的生物毒性檢測手段。80 年代初我國引進(jìn)了這項(xiàng)技術(shù),并先后分離出 海水型和淡水型(青;【┑陌l(fā)光細(xì)菌,用以檢測環(huán)境污染物的急性生物毒性。
一般發(fā)光細(xì)菌長約 1.5-3um(微米),寬度 0.5-0.8um,因此肉眼根本看不到,要用顯微 鏡放大至 1千倍時(shí)方可以分辨它們的體形。而它們的發(fā)光,也要在特定的條件中才能看得見。 青海弧菌是目前唯一的非致病型淡水發(fā)光菌,所以專利產(chǎn)品青;【鷥龈煞墼谶\(yùn)輸、使用過 程中安全可靠,對廢棄的菌液也不用進(jìn)行特殊處理,不會(huì)引起二次污染。
![]() |
| 培養(yǎng)皿中的發(fā)光細(xì)菌 |

使用微信“掃一掃”功能添加“谷騰環(huán)保網(wǎng)”